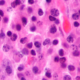

Top 20 Doctors + Others For Medicare Reimbursements in RI
GoLocalProv News Team
Top 20 Doctors + Others For Medicare Reimbursements in RI

Top 20 Medicare Payment Recipients in RI

20. Bayside Endoscopy LLC
Ambulatory Surgical Center
33 Staniford St., Providence
2012 Medicare Payment Data
Total Payment Amount: $906,270.96
Total Amount Requested: $4,973,041.00
Total Amount Allowed: $1,131,865.04
Number of Patients: 2,297

19. Scott Triedman
Radiation Oncology
825 N. Main St., Providence
2012 Medicare Payment Data
Total Payment Amount: $913,292.76
Total Amount Requested: $3,890,550.00
Total Amount Allowed: $1,146,103.50
Number of Patients: 221

18. Richard Bryan
Ophthalmology
120 Dudley St., Providence
2012 Medicare Payment Data
Total Payment Amount: $952,468.78
Total Amount Requested: $1,864,734.00
Total Amount Allowed: $1,214,139.31
Number of Patients: 688

17. Timothy Shafman
Radiation Oncology
115 Cass Ave., Woonsocket
2012 Medicare Payment Data
Total Payment Amount: $956,736.41
Total Amount Requested: $3,932,391.04
Total Amount Allowed: $1,200,057.52
Number of Patients: 195

16. City of Warwick
Ambulance Service Supplier
140 Veterans Memorial Dr., Warwick
2012 Medicare Payment Data
Total Payment Amount: $998,365.17
Total Amount Requested: $2,066,796.57
Total Amount Allowed: $1,257,678.93
Number of Patients: 1,805

15. John Przygoda
Hematology/Oncology
215 Toll Gate Rd., Warwick
2012 Medicare Payment Data
Total Payment Amount: $1,004,675.10
Total Amount Requested: $2,066,796.57
Total Amount Allowed: $1,261,926.16
Number of Patients: 503

14. Candescent Eye Surgicenter LLC
Ambulatory Surgical Center
444 Quaker Ln., Warwick
2012 Medicare Payment Data
Total Payment Amount: $1,006,561.31
Total Amount Requested: $2,627,000.00
Total Amount Allowed: $1,271,196.23
Number of Patients: 1,085

13. Harold Woodcome
Ophthalmology
690 Eddy St., Providence
2012 Medicare Payment Data
Total Payment Amount: $1,016,205.81
Total Amount Requested: $1,830,849.25
Total Amount Allowed: $1,287,778.13
Number of Patients: 610

12. Magdelena Krzystolik
Ophthalmology
1 Randall Sq., Providence
2012 Medicare Payment Data
Total Payment Amount: $1,179,376.11
Total Amount Requested: $2,298,560.00
Total Amount Allowed: $1,493,926.23
Number of Patients: 845

11. Daniel Esmaili
Ophthalmology
690 Eddy St., Providence
2012 Medicare Payment Data
Total Payment Amount: $1,206,315.63
Total Amount Requested: $2,822,677.88
Total Amount Allowed: $1,531,958.89
Number of Patients: 1,040

10. Robert Janigian
Ophthalmology
120 Dudley St., Providence
2012 Medicare Payment Data
Total Payment Amount: $1,239,967.62
Total Amount Requested: $2,404,494.00
Total Amount Allowed: $1,579,534.71
Number of Patients: 707

9. City of Providence
Ambulance Service Supplier
25 Dorrance St., Providence
2012 Medicare Payment Data
Total Payment Amount: $1,676,474.04
Total Amount Requested: $3,161,123.57
Total Amount Allowed: $2,101,837.97
Number of Patients: 2,594

8. New England Ambulance Service Inc.
Ambulance Service Supplier
31 Manuel Ave., Johnston
2012 Medicare Payment Data
Total Payment Amount: $1,776,635.86
Total Amount Requested: $5,659,733.00
Total Amount Allowed: $2,283,383.80
Number of Patients: 4,007

7. Universal Ambulance Service Inc.
Ambulance Service Supplier
457 Douglas Ave., Providence
2012 Medicare Payment Data
Total Payment Amount: $1,884,482.01
Total Amount Requested: $4,342,289.00
Total Amount Allowed: $2,373,620.07
Number of Patients: 2,140

6. Professional Ambulance LLC
Ambulance Service Supplier
52 River Ave., Providence
2012 Medicare Payment Data
Total Payment Amount: $1,958,350.32
Total Amount Requested: $4,714,047.00
Total Amount Allowed: $2,451,287.41
Number of Patients: 1,559

5. Jonah Licht
Internal Medicine
100 Highland Ave., Providence
2012 Medicare Payment Data
Total Payment Amount: $3,169,359.75
Total Amount Requested: $12,629,104.00
Total Amount Allowed: $4,041,718.40
Number of Patients: 652

4. Fathalla Mashali
Anesthesiology
42 Hemingway Dr., East Providence
2012 Medicare Payment Data
Total Payment Amount: $3,470,467.27
Total Amount Requested: $13,595,131.73
Total Amount Allowed: $3,698,641.98
Number of Patients: 727

3. Med Tech Ambulance Service Inc.
Ambulance Service Supplier
19 Mendon Ave., Pawtucket
2012 Medicare Payment Data
Total Payment Amount: $4,650,676.77
Total Amount Requested: $9,264,381.25
Total Amount Allowed: $5,834,893.12
Number of Patients: 6,291

2. East Side Clinical Lab Inc.
Clinical Laboratory
10 Risho Ave., East Providence
2012 Medicare Payment Data
Total Payment Amount: $7,133,560.47
Total Amount Requested: $25,254,372.28
Total Amount Allowed: $7,170,862.69
Number of Patients: 40,842

1. Dominion Diagnostics LLC
Clinical Laboratory
211 Circuit Dr., North Kingstown
2012 Medicare Payment Data
Total Payment Amount: $12,551,313.22
Total Amount Requested: $15,083,697.99
Total Amount Allowed: $12,616,086.69
Number of Patients: 20,736